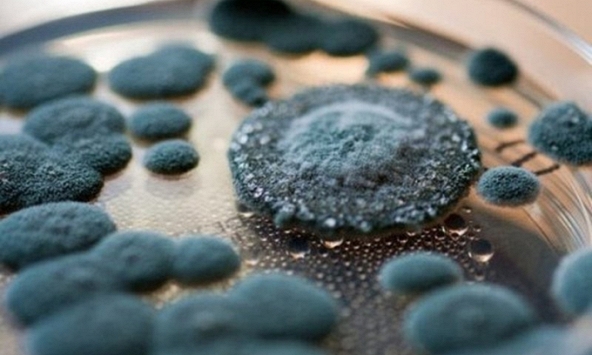
Vào tháng Chạp đừng để trong nhà xuất hiện thứ này vì là dấu hiệu của sự không may và nguy cơ ung thư, mưa rét càng dễ sinh sôi

1. Màu sắc bàn tay hồng hào
Bàn tay của người có tình trạng sức khoẻ tốt thường có màu hồng đỏ. Nguyên nhân là bởi khi máu lưu thông ổn định, lượng máu cung cấp đến các chi đủ sẽ khiến bàn tay có sắc hồng hào. Ngược lại, nếu tay nhợt nhạt nên cảnh giác với bệnh thiếu máu.
![]() |
Ngoài ra, nếu da tay chuyển màu vàng, rất có thể đây là tình trạng khởi phát của bệnh vàng da. Có rất nhiều nguyên nhân để dẫn đến chứng bệnh này bao gồm các bệnh về hệ tuần hoàn máu, gan hoặc tuyến tuỵ.
2. Hình dạng bàn tay không có sự thay đổi bất thường
Nhiều bệnh có thể gây ra các biến đổi cũng như dị tật ở bàn tay.
Ví dụ, ung thư phổi có thể gây ra hình dạng ngón tay dùi trống. Nguyên nhân cơ bản là bởi ngón tay do thiếu oxy tuần hoàn ngoại biên khiến máu giải phóng một loạt chất hoạt mạch như 5-hydroxytryptamine, prostaglandin... Những chất hoạt mạch này gây giãn mạch máu cục bộ và theo thời gian sẽ tạo ra các mô mềm tăng sản. Phổi là cơ quan cung cấp oxy nên khi có bất thường ở phổi, khả năng xảy ra hiện tượng ngón tay dùi trống.
Cùng với đó, viêm khớp dạng thấp có thể gây dị tật ngón tay; bệnh gút cũng có thể gây dị tật ngón tay và hình thành hạt tophi ở bàn tay. Chính vì vậy, khi xảy ra các bất thường gây biến dạng bàn tay, tốt nhất người bệnh cần đặc biệt lưu ý.
3. Móng tay hồng hào, sáng bóng
Hình dạng móng tay có thể trực tiếp hoặc gián tiếp phản ánh các bệnh lý như nấm móng có thể khiến móng bị biến đổi, chuyển màu, dễ giòn, dày hoặc gãy... Nếu vi sinh vật lây nhiễm vào các mô mềm xung quanh có thể gây ra phản ứng viêm cục bộ.
![]() |
Cùng với đó, những bệnh nhân mắc chứng cường giáp, thiếu máu do thiếu sắt có thể khiến móng tay bị trũng xuống hay còn gọi là móng tay lõm hình thìa.
Không chỉ vậy, màu sắc trên ngón tay cũng có thể phản ánh tình trạng sức khoẻ. Nếu trên móng tay xuất hiện các đường màu đen có thể do bệnh ngoài da, chấn thương, nốt sần ở móng hoặc do khối u ác tính gây ra.
4. Lực tay khoẻ
Một nhóm nghiên cứu thuộc Đại học Michigan (Mỹ) đã thu thập dữ liệu của 1.275 đối tượng tiến hành theo dõi chặt chẽ trong 10 năm. Kết quả cho thấy sức cầm nắm kém, yếu cơ và thiếu testosterone có mối tương quan chặt chẽ với nguy cơ mắc nhiều loại bệnh ở nam giới ở mọi lứa tuổi cũng như tình trạng lão hoá ở phụ nữ.
5. Tay không xuất hiện tình trạng tê đau bất thường
![]() |
Có nhiều nguyên nhân dẫn đến tê tay, có thể do thoái hoá đốt sống thắt lưng do ngồi lâu một chỗ hoặc làm việc quá sức gây chèn ép dây thần kinh, cũng có thể do bệnh tiểu đường, do chế độ ăn uống không hợp lý, lười vận động, căng thẳng dẫn đến rối loạn chuyển hoá các sợ dây thần kinh.
Ngoài ra, các bệnh về mạch máu não, bệnh rỗng tuỷ, u tuỷ sống, viêm dây thần kinh ngoại vi,… cũng có thể gây tê tay. Vì vậy, nếu bị tê tay kéo dài thì bạn cần chú ý đi khám sức khoẻ.
Bàn tay chúng ta có mối quan hệ mật thiết với não và tim. Nếu có bất thường ở não như nhồi máu não cấp tính, người bệnh thường bị tê và đau tay bất thường. Ví dụ như khi xảy ra nhồi máu cơ tim cấp tính, người bệnh sẽ đau bất thường ở các ngón tay.
6. Tay ấm
Bàn tay lạnh thường liên quan đến bệnh thiếu máu do máu lưu thông không đến các đầu ngón tay, ngón chân kịp thời. Ngoài ra, lòng bàn tay lạnh cũng có thể liên quan đến cảm lạnh, nhồi máu cơ tim, suy tim, viêm cơ tim, bệnh tim do tăng huyết áp và các bệnh khác. Chính vì vậy, việc có một bàn tay ấm áp có thể là dấu hiệu đẩy lùi những nỗi lo về bệnh tật.
Nguồn: Sohu

Lộ diện chân dung thủ khoa toàn quốc các môn trong kỳ thi HSG quốc gia năm nay, họ là ai?
Vào tháng Chạp đừng để trong nhà xuất hiện thứ này vì là dấu hiệu của sự không may và nguy cơ ung thư, mưa rét càng dễ sinh sôi
Cô dâu xinh đẹp nhưng thái độ lạ trong đám cưới, biết câu chuyện phía sau ai cũng thương cảm
24 tuổi đã bị ung thư ruột nhắm tới chỉ bởi một thức uống "vui miệng", bác sĩ cảnh báo thói xấu nhiều người hay mắc
Trên cơ thể có 4 “điểm trường thọ”, xoa bóp thường xuyên giúp ngừa ung thư mà không tốn 1 xu
Những người "khó" mắc ung thư thường có 6 điểm chung, hầu hết đều có thể học theo
Cùng chuyên mục
Nghiên cứu mới lý giải vì sao phụ nữ có nguy cơ mắc Alzheimer cao hơn nam giới
Vinmec Hạ Long nội soi bóc tách thành công khối u hiếm gặp, giữ trọn khả năng sinh sản cho người bệnh trẻ
4 thói quen điển hình của nhiều phụ nữ Việt đang làm tăng nguy cơ mắc bệnh phụ khoa, ung thư buồng trứng cũng trong "tầm ngắm"
Người phụ nữ 50 tuổi không uống rượu hay hút thuốc, ho suốt 1 tháng: Đi khám phát hiện thứ gây sốc ở tim
Chắp cánh ước mơ làm cha mẹ trong “Tuần lễ vàng – ươm mầm hạnh phúc 2026”
Mạch máu có tắc hay không, nhìn vùng đầu là biết: Nếu xuất hiện 4 dấu hiệu này, cần đến viện ngay